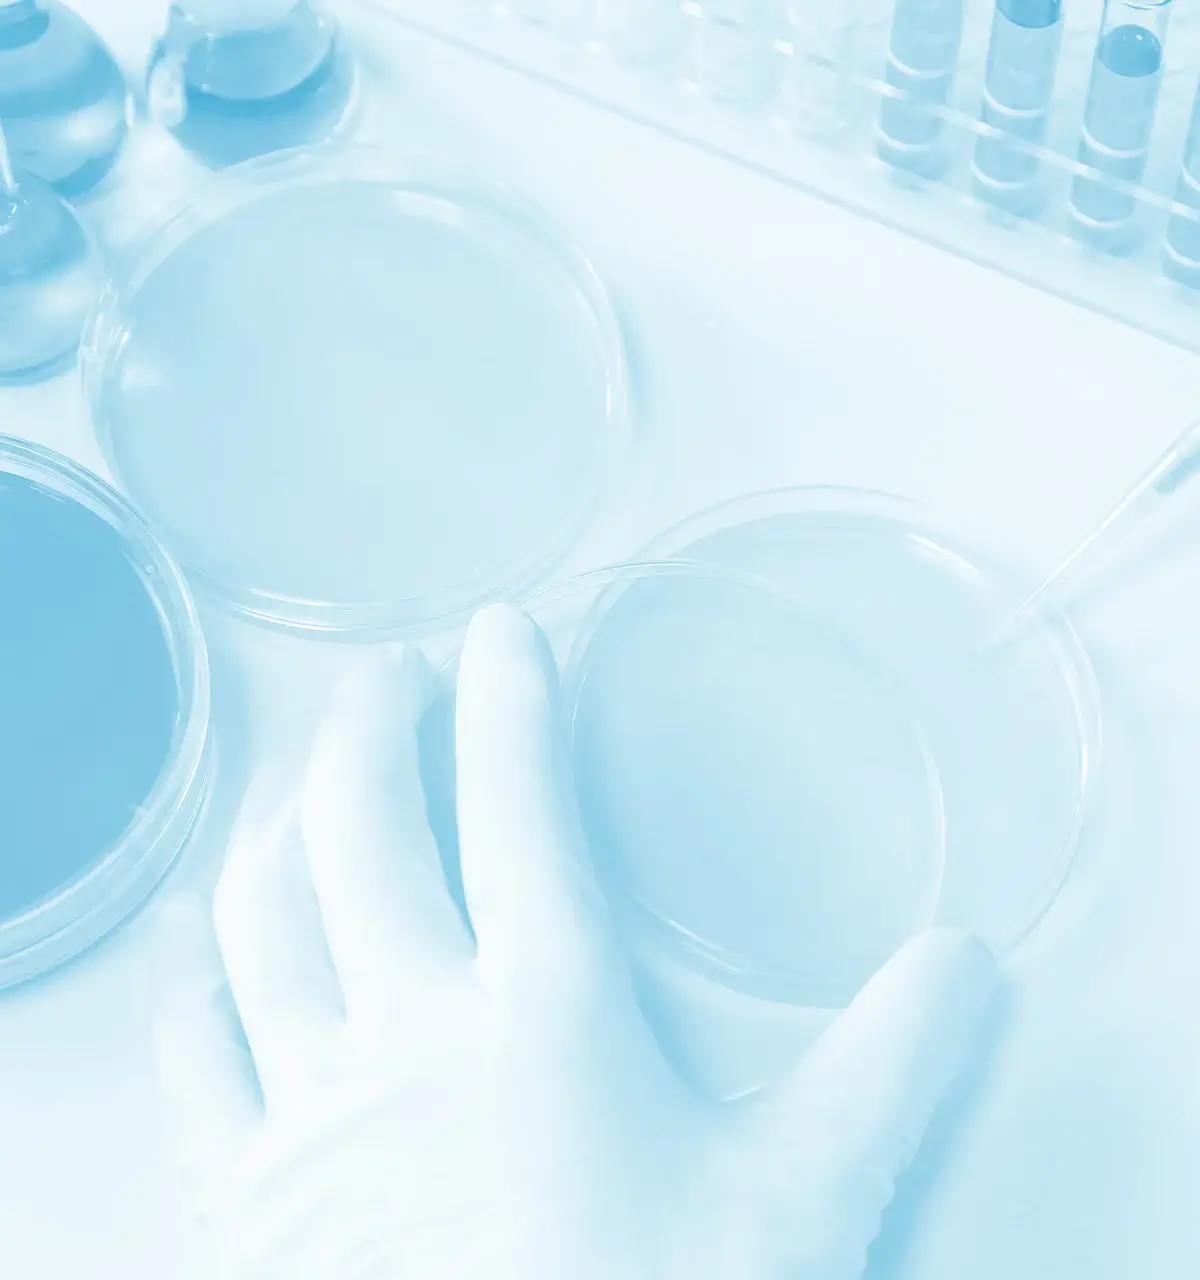

particular 安全性へのこだわり
日田天領水は、お客様に安全で安心なミネラルウォーターを提供するため
国際的な食品安全規格を多層的に導入し、徹底した衛生管理体制を構築しています。

management 衛生管理
私たちの理念「日本をはじめ世界の人々の健康を願って」には、日田天領水で健やかな毎日を届けたいという想いが込められています。
工場ではHACCP・ISO22000・FSSC22000を導入し、徹底した衛生管理で安全・安心な製品づくりを実現しています。